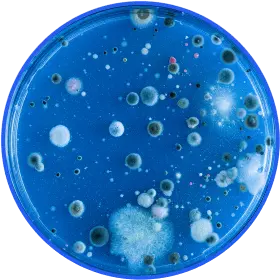

4.8 | (372 reviews)
4.8 | (372 reviews)
Powerful & Natural Pesticide Device: Zap the Bed Bugs & Dust Mites Hiding In Your Room, Pillow, Mattress, & More... ✅100% Guaranteed
The Swissker HaloUV uses natural UV light and ozone to refresh any room. UV light and ozone are shown to be effective tools against pests – and now you can use it at home WITHOUT toxic chemicals!
- Targets bed bug eggs and other pests – as well as household odors that stick to your clothes and skin.
- The HaloUV is a natural pesticide device with natural UV and ozone power.
- 360° Cleaning Power Coverage: Penetrates deep into pillows & mattresses.
- Remote Control: Convenient & easy to use.
- Clinical strength UV light that refreshes your home without the chemicals and toxins found in some aerosol sprays.
- 90-Day Money-Back Guarantee.
-
Stock up today for a full protection

-
Fast USA Delivery in 3-5 Days
-
Risk-Free Purchase - 90-Day Money-Back Guarantee